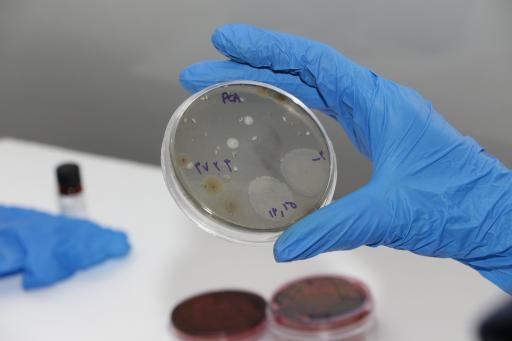
عکس آزمایشگاه تخصصی پرتو بشاش

©OpenStreetMap Contributors©Neshan
 شمال
شمال نمایش موقعیت من
نمایش موقعیت من

آزمایشگاه تخصصی پرتو بشاش
5/0



 3 رای
3 رای
آزمایشگاه تشخیص طبی
۸ تا ۱۷
- دوشنبه (امروز)۸ تا ۱۷
- سهشنبه۸ تا ۱۷
- چهارشنبه۸ تا ۱۷
- پنجشنبه۸ تا ۱۵
- جمعهتعطیل
- شنبه۸ تا ۱۷
- یکشنبه۸ تا ۱۷
ﺑﻪ اﯾﻦ ﻣﮑﺎن اﻣﺘﯿﺎز دﻫﯿﺪ




- تهران
- /
- آزمایشگاههای تهران
- /
- آزمایشگاه تخصصی پرتو بشاش
آزمایشگاههای پیشنهادی در نزدیکی آزمایشگاه تخصصی پرتو بشاش
امکانات نزدیک
سرویس بهداشتی
خودپرداز
دستهبندیهای مرتبط با آزمایشگاه تخصصی پرتو بشاش
ﺑﻪ اﯾﻦ ﻣﮑﺎن اﻣﺘﯿﺎز دﻫﯿﺪ
نظرات دربارهی آزمایشگاه تخصصی پرتو بشاش
![مدیر کسبوکار]() مدیر کسبوکار1402/10/27
مدیر کسبوکار1402/10/27- گزارش نظر
عالی و کامل
1 لایک
تصاویر آزمایشگاه تخصصی پرتو بشاش
- ۲ سال پیش
![عکس آزمایشگاه تخصصی پرتو بشاش عکس آزمایشگاه تخصصی پرتو بشاش]()
- ۲ سال پیش
![عکس آزمایشگاه تخصصی پرتو بشاش عکس آزمایشگاه تخصصی پرتو بشاش]()
- ۲ سال پیش
![عکس آزمایشگاه تخصصی پرتو بشاش عکس آزمایشگاه تخصصی پرتو بشاش]()
- ۲ سال پیش
![عکس آزمایشگاه تخصصی پرتو بشاش عکس آزمایشگاه تخصصی پرتو بشاش]()
دربارهی آزمایشگاه تخصصی پرتو بشاش
آزمایشگاه تخصصی پرتو بشاش (آزمایشگاه تشخیص طبی) در محله شهرک پرواز تهران و خیابان هشتم شرقی واقع شده است. این مکان یکی از سه آزمایشگاه تشخیص طبی در محله شهرک پرواز تهران میباشد و از نظر موقعیت جغرافیایی در نزدیکی پاساژ آبگینه و همچنین مسجد حضرت زینب (س)، داروخانه و پت شاپ سانا، کترینگ رویای سبز، استخر و باشگاه بدنسازی موج خورشید و استخر موج خورشید تهران قرار گرفته است. با توجه به نزدیکی این مکان به ایستگاه مترو علامه جعفری، برای دسترسی راحتتر و کمک به داشتن هوایی پاکتر، میتوانید از وسایل حمل و نقل عمومی برای مراجعه به آن استفاده کنید.















